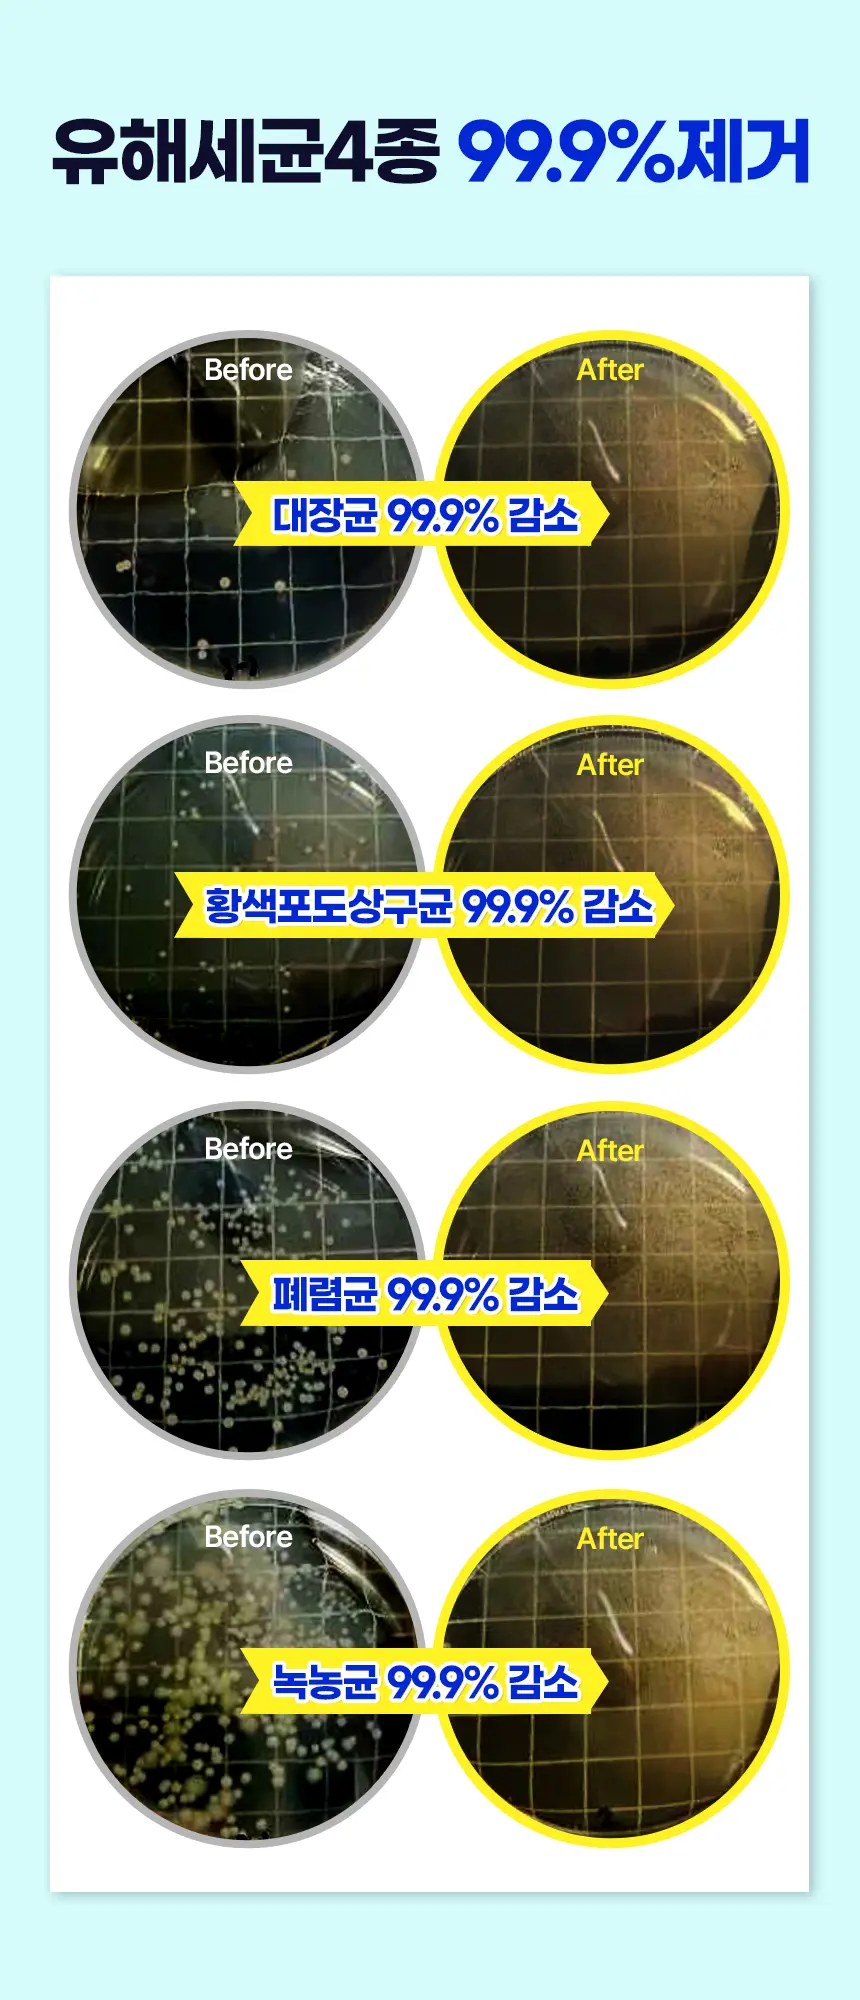
https://cdn.cashreview.kr/production/campaign/detail-content/043a0ec3-e275-4341-814b-4439869d966e.png

1. 후기를 성의 없게 작성한 참여자는 추후 캠페인 당첨에서 제외될 확률이 높습니다.
2. 캠페인 당첨 후 후기를 작성하지 않은 경우, 제품 비용이 청구될 수 있으며 추후 캠페인 당첨에 불이익을 받을 수 있습니다.
3. 캠페인으로 발생한 모든 콘텐츠는 2차 마케팅 용도로 활용될 수 있습니다.
4. 후기 작성 후, 반드시 후기 등록을 해주셔야 합니다. (미등록 시 미작성자로 간주)
5. 후기 가이드와 맞지 않는 후기로 인해, 수정 안내 알림톡이 발송됩니다. 최대한 빠르게 수정 부탁드립니다.
6. 다른 사람이 작성한 캠페인 후기를 카피할 경우, 추후 캠페인 당첨에서 제외됩니다.
7. 동일 캠페인 재참여 시 기존 후기를 복사하여 작성 불가합니다. 새로운 내용으로 후기글 작성 부탁드립니다.
8. 캠페인으로 제공된 제품은 중고거래가 절대 불가하며, 주소 대표로 적발 가능합니다.적발 시, 영구정지 처리됩니다.
9. 작성하신 후기는 6개월 유지해야 하며, 유지하지 않을 경우 페널티가 부과됩니다.